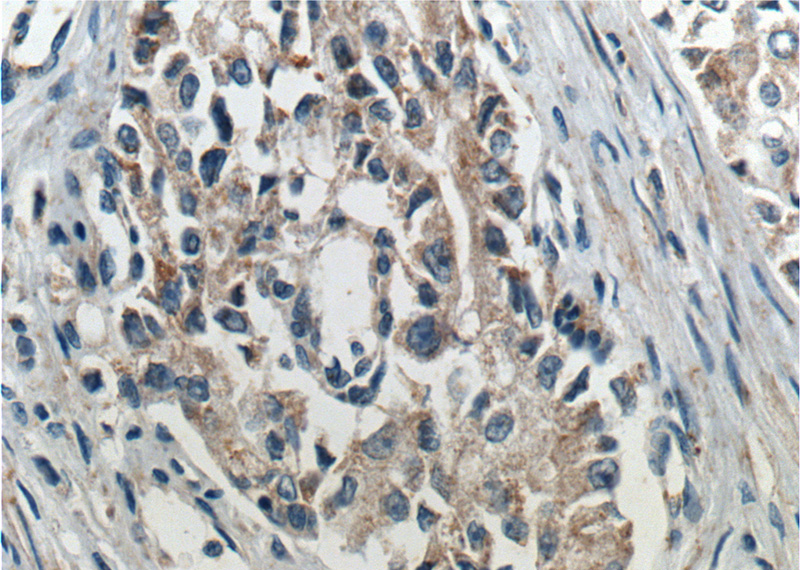
Immunohistochemistry of paraffin-embedded human prostate cancer tissue slide using Catalog No:114264(PTEN Antibody) at dilution of 1:200 (under 40x lens). heat mediated antigen retrieved with Tris-EDTA buffer(pH9).

-
Product Name
PTEN antibody
- Documents
-
Description
PTEN Rabbit Polyclonal antibody. Positive WB detected in DU 145 cells, HeLa cells, MKN-45 cells, mouse thymus tissue. Positive IHC detected in human prostate cancer tissue, human breast cancer tissue, human colon cancer tissue, human testis tissue, mouse brain tissue. Positive IF detected in HeLa cells. Observed molecular weight by Western-blot: 65-68 kDa
-
Tested applications
ELISA, IHC, WB, IF
-
Species reactivity
Human, Mouse; other species not tested.
-
Alternative names
10q23del antibody; Bannayan Zonana syndrome antibody; BC005821 antibody; BZS antibody; ITGA 2 antibody; MGC11227 antibody; MHAM antibody; MMAC1 antibody; Multiple hamartoma (Cowden syndrome) antibody; phosphatase and tensin homolog antibody; PTEN antibody; PTEN1 antibody; TEP1 antibody
-
Isotype
Rabbit IgG
-
Preparation
This antibody was obtained by immunization of PTEN recombinant protein (Accession Number: NM_000314). Purification method: Antigen affinity purified.
-
Clonality
Polyclonal
-
Formulation
PBS with 0.02% sodium azide and 50% glycerol pH 7.3.
-
Storage instructions
Store at -20℃. DO NOT ALIQUOT
-
Applications
Recommended Dilution:
WB: 1:200-1:2000
IHC: 1:20-1:200
IF: 1:50-1:500
-
Validations

DU 145 cells were subjected to SDS PAGE followed by western blot with Catalog No:114264(PTEN Antibody) at dilution of 1:600

Immunohistochemistry of paraffin-embedded human prostate cancer tissue slide using Catalog No:114264(PTEN Antibody) at dilution of 1:200 (under 10x lens). heat mediated antigen retrieved with Tris-EDTA buffer(pH9).
Immunohistochemistry of paraffin-embedded human prostate cancer tissue slide using Catalog No:114264(PTEN Antibody) at dilution of 1:200 (under 40x lens). heat mediated antigen retrieved with Tris-EDTA buffer(pH9).

Immunofluorescent analysis of (10% Formaldehyde) fixed HeLa cells using Catalog No:114264(PTEN Antibody) at dilution of 1:50 and Alexa Fluor 488-congugated AffiniPure Goat Anti-Rabbit IgG(H+L)
-
Background
PTEN(Phosphatase and tensin homolog) is also named as MMAC1, TEP1 and it modulates cell cycle progression and cell survival (blockage) through down-regulating the positive cell cycle-regulator (cycle D1) by its phosphatase activity and up-regulating the negative cell cycle regulator p21 (by its lipid phosphatase activity). PTEN is an important tumor suppressor whose inactivation frequency in cancers is ranked second after p53 tumor suppressor inactivation. PTEN is a 403-residue protein structured in an amino (N)-terminal phosphatase domain and a carboxy (C)-terminal C2 domain that binds phospholipid membranes.(PMID:14749127). There are some report showing that SUMOylation appears to be a positive regulator in controlling PTEN membrane association, whereas phosphorylation is a negative regulator that may neutralize SUMOylation through intramolecular electrostatic interactions (PMID:22713753). This protein has 3 isoforms produced by alternative splicing and alternative initiation with the MW of 47, 65, 20 kDa.
-
References
- Carvalho KC, Maia BM, Omae SV. Best practice for PTEN gene and protein assessment in anatomic pathology. Acta histochemica. 116(1):25-31. 2014.
- Feng Y, Liu J, Kang Y. miR-19a acts as an oncogenic microRNA and is up-regulated in bladder cancer. Journal of experimental & clinical cancer research : CR. 33:67. 2014.
- Eritja N, Santacana M, Maiques O, Gonzalez-Tallada X, Dolcet X, Matias-Guiu X. Modeling glands with PTEN deficient cells and microscopic methods for assessing PTEN loss: endometrial cancer as a model. Methods (San Diego, Calif.). 77-78:31-40. 2015.
Related Products / Services
Please note: All products are "FOR RESEARCH USE ONLY AND ARE NOT INTENDED FOR DIAGNOSTIC OR THERAPEUTIC USE"
